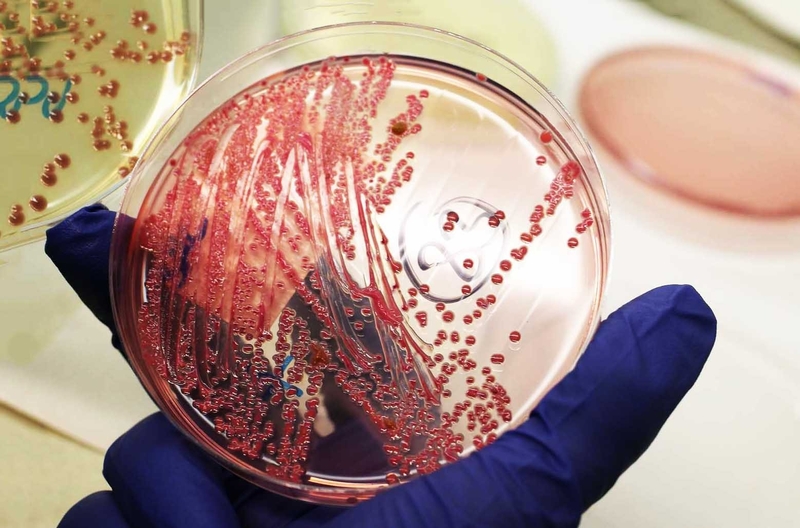
Xét nghiệm cấy đờm là gì? Có tác dụng như thế nào? 1

Dược sĩ Đại học có nhiều năm kinh nghiệm trong việc tư vấn Dược phẩm và hỗ trợ giải đáp thắc mắc về Bệnh học. Hiện đang là giảng viên cho Dược sĩ tại Nhà thuốc Long Châu.
Thu Hoà
18/04/2024
Mặc định
Lớn hơn
Bạn đã bao giờ tự hỏi làm thế nào các bác sĩ xác định nguyên nhân của các vấn đề hô hấp như viêm phổi hay viêm phế quản, một cách chính xác và chi tiết chưa? Hãy cùng tìm hiểu về xét nghiệm cấy đờm - trợ thủ đắc lực của các bác sĩ.
Xét nghiệm cấy đờm là một phương pháp quan trọng và quen thuộc thường được áp dụng để phân tích mẫu đờm từ bệnh nhân, giúp chẩn đoán và xác định loại vi khuẩn hoặc nấm gây ra nhiễm trùng trong hệ hô hấp. Trong bối cảnh y học ngày nay, xét nghiệm này không chỉ đơn thuần là một công cụ chẩn đoán mà còn là trợ thủ quan trọng giúp bác sĩ xác định phương pháp điều trị hiệu quả. Hãy cùng chúng tôi khám phá chi tiết hơn về xét nghiệm cấy đờm và những trường hợp cần thực hiện xét nghiệm này thông qua bài viết dưới đây.
Đã bao giờ bạn tự hỏi làm thế nào mà xét nghiệm cấy đờm lại có thể giúp bác sĩ xác định nguyên nhân của bệnh và hỗ trợ việc đưa ra quyết định điều trị chính xác chưa?
Trên thực tế, xét nghiệm cấy đờm hoạt động dựa trên việc thu mẫu đờm từ bệnh nhân và đặt mẫu này vào môi trường nuôi cấy. Mục tiêu là tạo điều kiện lý tưởng để các vi khuẩn phát triển. Nếu vi khuẩn có mặt trong mẫu, chúng sẽ phát triển và tạo thành các đám mầm hoặc cụm tế bào, có thể được quan sát và đếm dưới kính hiển vi.
Quá trình này giúp xác định loại vi khuẩn gây nhiễm trùng và cung cấp thông tin chi tiết về mức độ nhiễm trùng. Điều này giúp bác sĩ có thể xác định phương pháp điều trị chính xác, từ đó đảm bảo chăm sóc sức khỏe hiệu quả và ngăn chặn sự phát triển của bệnh. Cũng vì vậy mà xét nghiệm cấy đờm không chỉ là một bước quan trọng trong quá trình chẩn đoán bệnh mà còn là công cụ quan trọng hỗ trợ việc điều trị và theo dõi tiến triển của bệnh nhân.
Hiện nay xét nghiệm cấy đờm được ứng dụng rộng rãi trong chẩn đoán và theo dõi các tình trạng y tế liên quan đến đường hô hấp. Dưới đây là một số bệnh có thể ứng dụng kết quả của xét nghiệm này các bạn có thể tham khảo:

Ứng dụng linh hoạt của xét nghiệm cấy đờm sẽ giúp bác sĩ đưa ra quyết định chính xác về phương pháp điều trị và chăm sóc sức khỏe đối với bệnh nhân. Từ đó giúp cải thiện khả năng khỏi bệnh và phục hồi của bệnh nhân
Vậy những đối tượng nào nên thực hiện xét nghiệm cấy đờm có lẽ là thắc mắc của không ít người. Dưới đây là những người nên thực hiện xét nghiệm này mà các bạn có thể tham khảo:

Trong thực tế, việc thực hiện xét nghiệm cấy đờm đối với những người có triệu chứng hoặc yếu tố nguy cơ nhiễm trùng cao là một quyết định thông minh, giúp các bác sĩ có thể nhanh chóng đưa ra chẩn đoán chính xác, từ đó đảm bảo chăm sóc sức khỏe hiệu quả hơn và phòng ngừa lây nhiễm.
Xét nghiệm cấy đờm thường được thực hiện dưới sự hướng dẫn của bác sĩ khi cần thiết và đóng vai trò quan trọng trong việc xác định nguyên nhân của các vấn đề hô hấp và đưa ra quyết định chăm sóc sức khỏe phù hợp.
Với khả năng xác định chính xác loại vi khuẩn gây bệnh, xét nghiệm cấy đờm sẽ giúp bác sĩ cá nhân hóa phương pháp điều trị, từ đó góp phần làm tăng khả năng phục hồi và giảm việc sử dụng thuốc kháng sinh không cần thiết. Xét nghiệm cấy đờm không chỉ là công cụ quan trọng trong suốt quá trình điều trị bệnh mà còn là một phần không thể thiếu trong nỗ lực để bảo vệ sức khỏe cộng đồng trên toàn cầu.
Xem thêm:
Dược sĩ Đại họcNguyễn Mỹ Huyền
Dược sĩ Đại học có nhiều năm kinh nghiệm trong việc tư vấn Dược phẩm và hỗ trợ giải đáp thắc mắc về Bệnh học. Hiện đang là giảng viên cho Dược sĩ tại Nhà thuốc Long Châu.